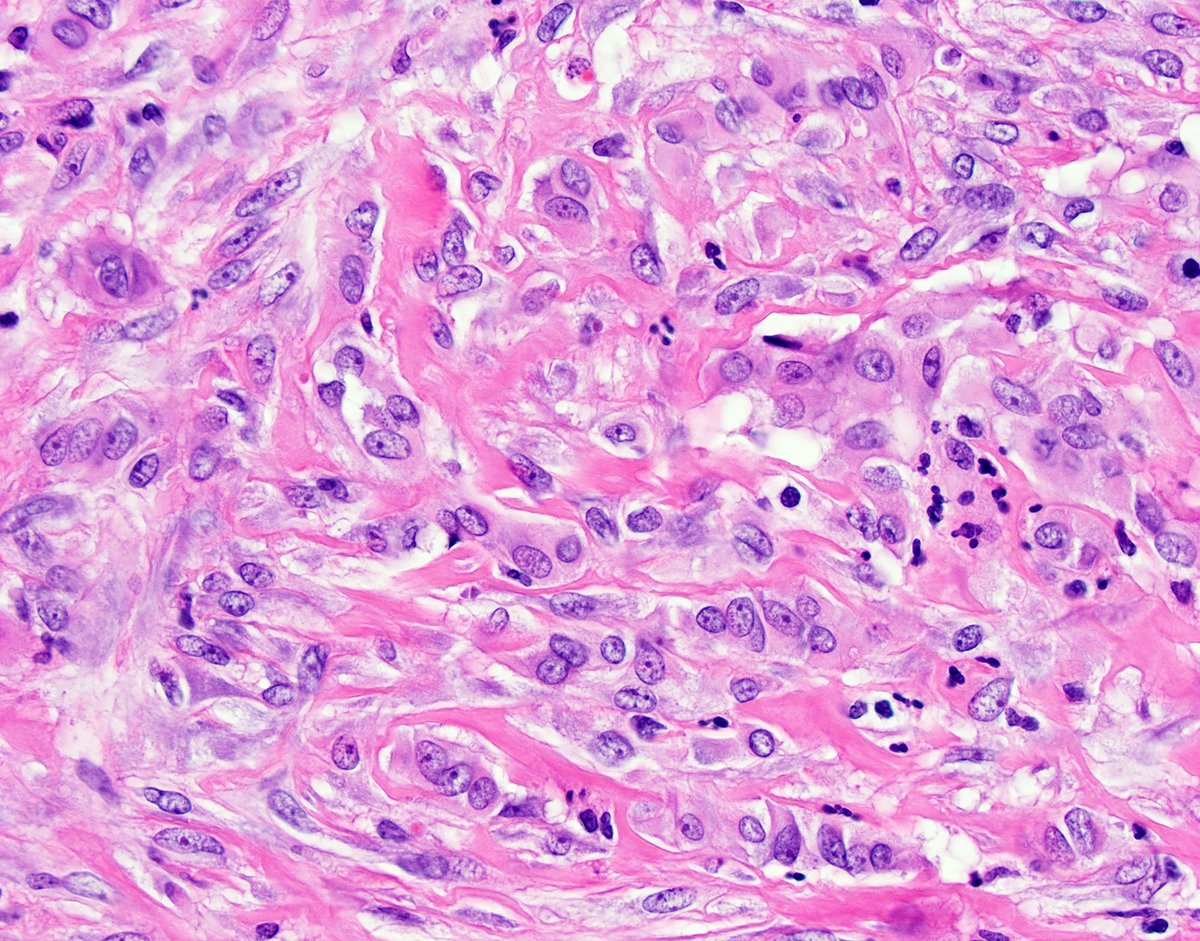
David Hernandez Gonzalo tweet media

David Hernandez Gonzalo
159 posts


David Hernandez Gonzalo
@DHGGIpath
I have a passion for GI and Liver Pathology. I was blessed to have great mentors and cofellow. Serrated lesions is my favorite area.
University of Florida Gainesvi Katılım Eylül 2019
1.2K Takip Edilen842 Takipçiler

@RaulSGonzalezMD @ALBoothMD So 13 stellar pathologists. I will definitely buy it.
English

Available online now and in print soon: Check out the latest issue of Surgical Pathology Clinics, with 12 great gastrointestinal pathology articles from a stellar lineup of authors! (and me) bit.ly/3gXZQWe amazon.com/dp/0323758800/ #pathology #gipath


English

Imagine we are in Pathology Boards in Tampa (10/2020) and you have a young female in her 20s with spotty skin pigmentation and tumors in thyroid and breast (see next tweet). What gene would you select for your multiple choice question? #pathology
English
David Hernandez Gonzalo retweetledi

Pitfall alert in perforated appendicitis: Detached CAM5.2 + cells can mimic malignancy. Key: calretinin coexpression and background organizing inflammation. Myofibroblasts appear in subserosal area around the perforation as highlighted with CAM5.2. #GIpath #pathology

English
David Hernandez Gonzalo retweetledi

Don't miss tomorrow's live CAP Virtual Lecture Series, "Survival Guide to Pediatric Tumors" w/ @ChildrensColo's @MArnold_PedPath at 10a CDT. Learn more & register: capatholo.gy/3ayRH7w. #PediPath #capvirtualpath

English
David Hernandez Gonzalo retweetledi

What do patients with cancer need to know about COVID-19? I've written this piece for @CancerDotNet that might be helpful. In English: buff.ly/3aJiBt1 In Spanish: buff.ly/2W5JGma

English

David Hernandez Gonzalo retweetledi

Great review of Hans Popper Journal Watch by the amazing Dr. Daniela Allende @Allende_DS @LiverPath_HPHS

English

@KristenStashek Best PowerPoint presentation I have seen in a long time @PancPathologist
English

Great lecture by Dr. Torbenson at Hans Popper Hepatopathology Society @LiverPath @LiverPath_HPHS


English
David Hernandez Gonzalo retweetledi

I’ve got a countdown ticker going... we are t-26 days until the launch of my book on #impostorsyndrome. Early reviews say it will be life changing! I’m so excited to be able to get the content of my live impostor syndrome program to so many more people!
English
David Hernandez Gonzalo retweetledi

Case of the week! Gallbladder with a poorly differentiated neuroendocrine carcinoma (PDNEC) arising in a background of an intracholecystic papillary-tubular neoplasm. Note that expression of Retinoblastoma protein is lost in the PDNEC component. #gallbladder #PDNEC #ICPN



English

DHG talks are amazing in ANY language!
David Hernandez Gonzalo@DHGGIpath
It was awesome meeting the residents and attendings from Hospital Ramon y Cajal in Madrid. Their Chairman Dr. Palacios, former President of the Spanish Society of Pathologists is a fantastic leader. Had my first Grand Round and Scope session in Spanish since 2008. #MambaMentality
English












